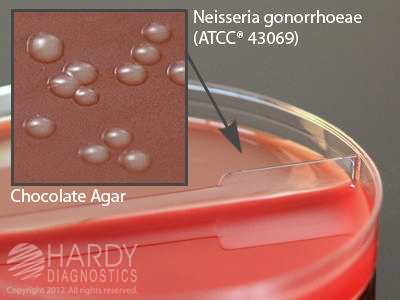

Blood Agar 5%Chocolate Biplate , Pack Of 10
$ 31.48
|
|
Details:
Blood agar 5%chocolate biplate
Additional Information
| SKU | 23587877 |
|---|---|
| UOM | Pack of 10 |
| UNSPSC | 41116104 |
| Manufacturer Part Number | J42 |
| Product Dimensions | 4X4X8 Inches |
| Product Weight | 1 |
